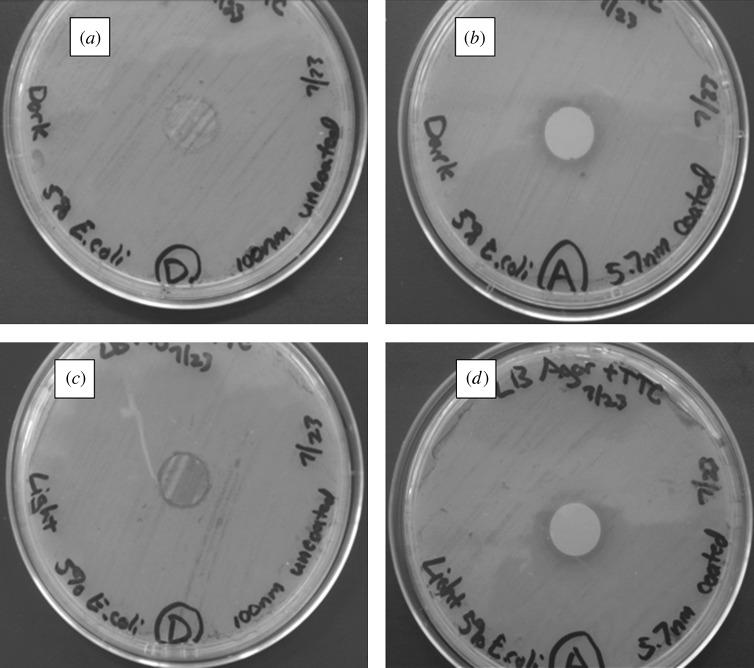

基于原子层沉积的材料功能化在医疗和环境健康应用中的研究进展。
Atomic layer deposition-based functionalization of materials for medical and environmental health applications.
机构信息
Joint Department of Biomedical Engineering, University of North Carolina and North Carolina State University, 2147 Burlington Engineering Labs, Raleigh, NC 27695-7115, USA.
出版信息
Philos Trans A Math Phys Eng Sci. 2010 Apr 28;368(1917):2033-64. doi: 10.1098/rsta.2010.0011.
Nanoporous alumina membranes exhibit high pore densities, well-controlled and uniform pore sizes, as well as straight pores. Owing to these unusual properties, nanoporous alumina membranes are currently being considered for use in implantable sensor membranes and water purification membranes. Atomic layer deposition is a thin-film growth process that may be used to modify the pore size in a nanoporous alumina membrane while retaining a narrow pore distribution. In addition, films deposited by means of atomic layer deposition may impart improved biological functionality to nanoporous alumina membranes. In this study, zinc oxide coatings and platinum coatings were deposited on nanoporous alumina membranes by means of atomic layer deposition. PEGylated nanoporous alumina membranes were prepared by self-assembly of 1-mercaptoundec-11-yl hexa(ethylene glycol) on platinum-coated nanoporous alumina membranes. The pores of the PEGylated nanoporous alumina membranes remained free of fouling after exposure to human platelet-rich plasma; protein adsorption, fibrin networks and platelet aggregation were not observed on the coated membrane surface. Zinc oxide-coated nanoporous alumina membranes demonstrated activity against two waterborne pathogens, Escherichia coli and Staphylococcus aureus. The results of this work indicate that nanoporous alumina membranes may be modified using atomic layer deposition for use in a variety of medical and environmental health applications.
介孔氧化铝膜具有高孔密度、可控且均匀的孔径以及直孔等特点。由于这些特殊的性质,介孔氧化铝膜目前被认为可用于植入式传感器膜和水净化膜。原子层沉积是一种薄膜生长工艺,可用于在保留窄孔径分布的情况下改变介孔氧化铝膜的孔径。此外,通过原子层沉积沉积的薄膜可以赋予介孔氧化铝膜更好的生物功能。在这项研究中,通过原子层沉积在介孔氧化铝膜上沉积了氧化锌和铂涂层。通过在铂涂层的介孔氧化铝膜上自组装 1-巯基十一烷-六(乙二醇)制备了聚乙二醇化介孔氧化铝膜。涂覆的膜表面没有观察到蛋白质吸附、纤维蛋白网络和血小板聚集。氧化锌涂层的介孔氧化铝膜对两种水生病原体大肠杆菌和金黄色葡萄球菌具有活性。这项工作的结果表明,介孔氧化铝膜可以通过原子层沉积进行修饰,用于各种医疗和环境卫生应用。